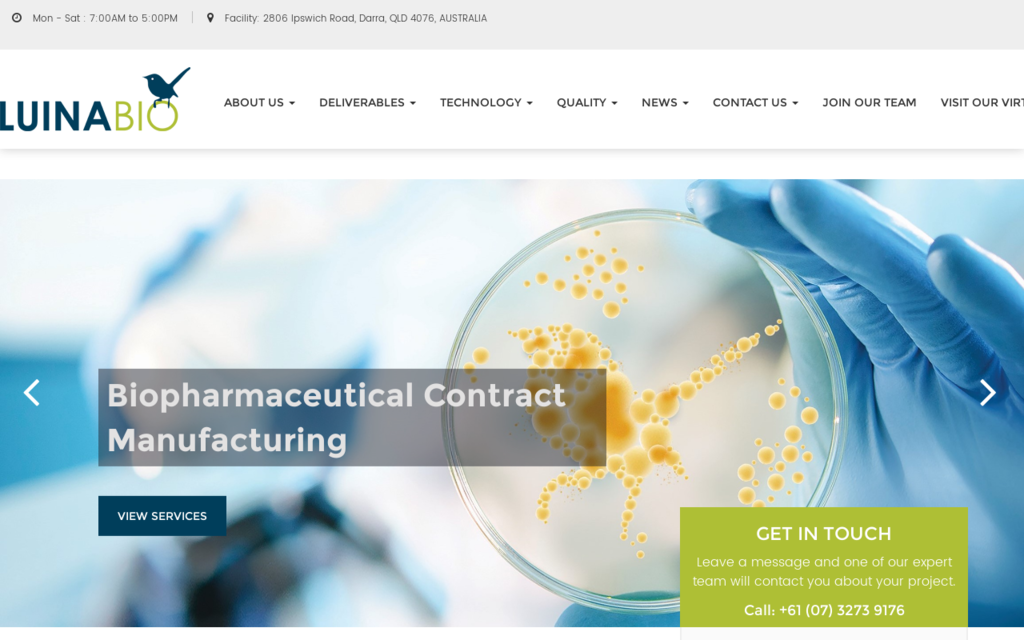

Health & Medical

-
 Clinical & General Diagnostics
Clinical & General Diagnostics -
 Health Research & Testing Services
Health Research & Testing Services -
 Health Supplement
Health Supplement -
 Hospital & Ward Nursing Equipment
Hospital & Ward Nursing Equipment -
 Medical & Healthcare Services
Medical & Healthcare Services -
 Medical Consumables
Medical Consumables -
 Medicines & Pharmaceuticals
Medicines & Pharmaceuticals -
 Nutraceuticals
Nutraceuticals -
 OR Equipment Clinical Instruments & Medical Devices
OR Equipment Clinical Instruments & Medical Devices -
 Rehabilitation & Mobility Aids
Rehabilitation & Mobility Aids -
 Wound Care & Dressings
Wound Care & Dressings
-
Clinical & General Diagnostics
-
Health Research & Testing Services
-
Health Supplement
-
Hospital & Ward Nursing Equipment
-
Medical & Healthcare Services
-
Medical Consumables
-
Medicines & Pharmaceuticals
-
Nutraceuticals
-
OR Equipment Clinical Instruments & Medical Devices
-
Rehabilitation & Mobility Aids
-
Wound Care & Dressings